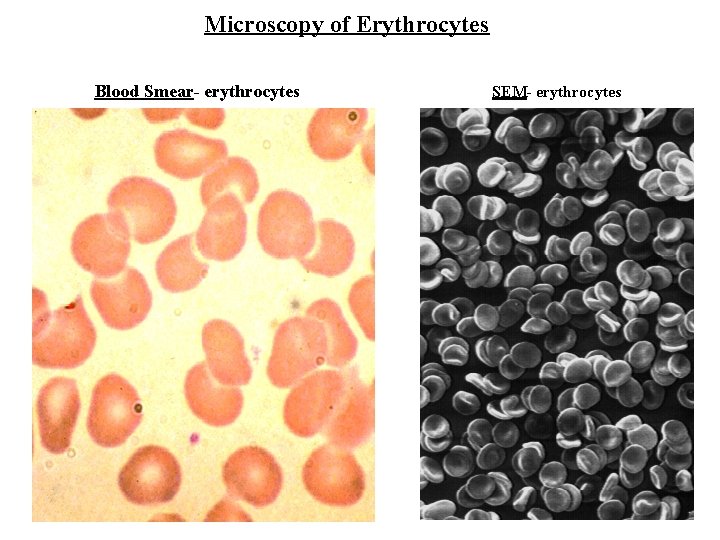
Microscopy of Erythrocytes Blood Smear- erythrocytes SEM- erythrocytes
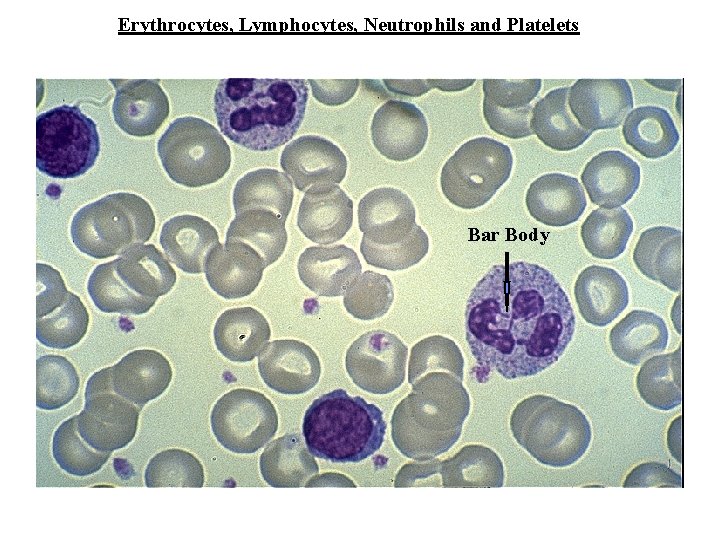
Erythrocytes, Lymphocytes, Neutrophils and Platelets Bar Body

Whole Blood Centrifuged with Anticoagulant Serum plasma minus

Whole Blood Centrifuged with Anticoagulant Serum - plasma minus fibrinogen Red Cells - 5 X 10 6 3 / mm 3 White Cells - 6 -9 X 10 / mm H 2 O -91 -92% Protein -7 -8% Electrolytes Nutrients Blood Gases Hormones 3 Hematocrit (volume RBC’s/unit plasma) males - 40 -50% females- 35 -40% Plasma (54%) Buffy Coat (1%) (white cells and platelets) Red Cells (45%) (erythrocytes)

Red Blood Cells (erythrocytes) 7. 5 -8. 5 um dia. stagnant blood- rouleaux Biconcave Discs rapidly-flowing blood Sickle Cells (valine-glutamine subst. b-hemoglobin chain) Erythrocyte Shape Varies with Tonicity Spherocytosis (spectrin alteration) hypertonic isotonic hypotonic (spheres) very hypotonic (ghosts)
Microscopy of Erythrocytes Blood Smear- erythrocytes SEM- erythrocytes

BLOOD PLATELETS (thrombocytes) microtubules glycogen Hyalomere Granulomere (pale blue) (purple granules) Platelet- light micrograph glycogen microtubules granules

Blood Clotting Prothrombin Thromboplastin (released from platelets and injured vessel wall) Thrombin Fibrinogen thrombus lesion Fibrin (clot) (feltwork of fibrils, platelets and blood cells) platelets

AGRANULAR LEUKOCYTES Lymphocytes (20 -25%) Monocytes (3 -8%) Mononuclear Phagocytic System Monocytes B Lymphocytes (humoral immunity) T-Lymphocytes (cell mediated immunity) Lymphocytes

GRANULAR LEUKOCYTES Neutrophil (PMN) (55 -65%) (polymorphonuclear leukocyte) Specific Granules (lysosomes & phagocytins 0 Azurophil Granules Lobes of Nucleus (lysosomes) Ectoplasmic Layer Neutrophil Specific Granules Pseudopodia
Erythrocytes, Lymphocytes, Neutrophils and Platelets Bar Body

GRANULAR LEUKOCYTES Eosinophils (1 -3%) Eosinophilic (acidophilic) granules (destroy antigen-antibody complexes) Eosinophil Crystals Specific Granules

Granular Leukocytes Basophils (less than 1%) Basophilic Granules heparin histamine serotonin Basophil

Eosinophil, Neutrophil and Basophil Eosinophil Neutrophil Basophil

Blood Plasma- transparent, yellow liquid vehicle for cells Serum- plasma without fibrinogen Serum Proteins: Albumin (@ 60 K) - colloid osmotic pressure and provide for solubility of hydrophobic components (e. i. lipids) Globulins (> 80 K) gamma globulins- e. i. Ig. G (immune globulins-antibodies) beta globulins - hormone transport (e. i. thyrogloblin) Transferrin- iron transport Cerruloplasmin- copper transport Serum Lipoproteins chylomicrons- fatty acid transport Very Low Density Lipoproteins (VLDL)) Low Density Lipoproteins (LDL) High Density Lipoproteins (HDL)
- Slides: 12